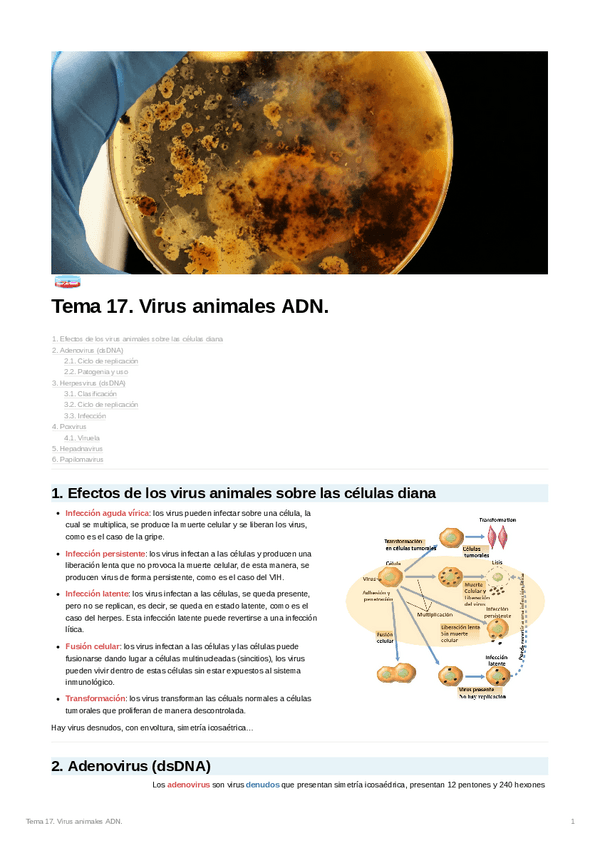
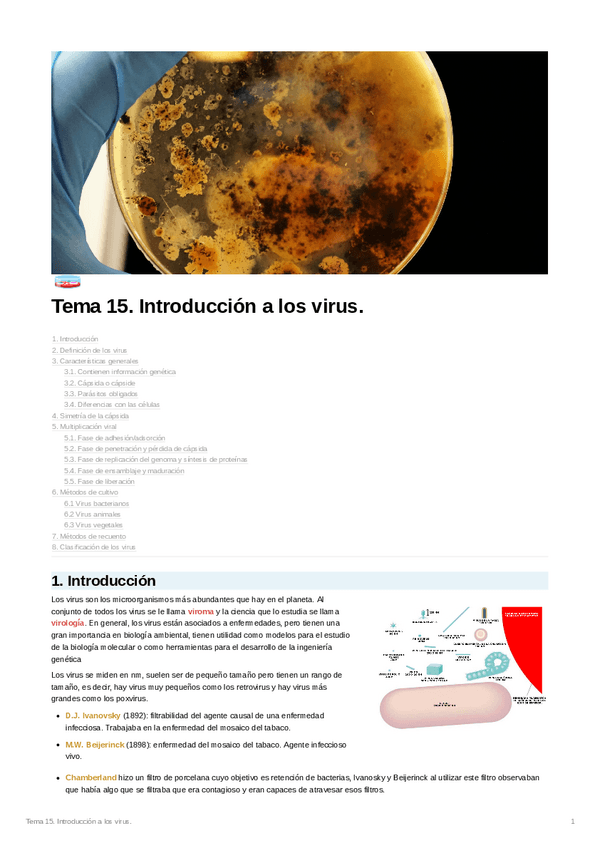
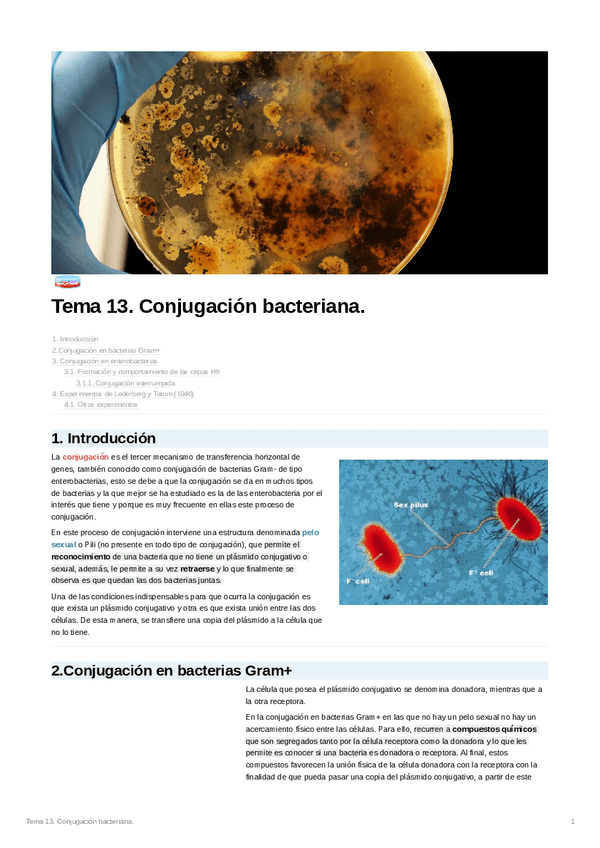
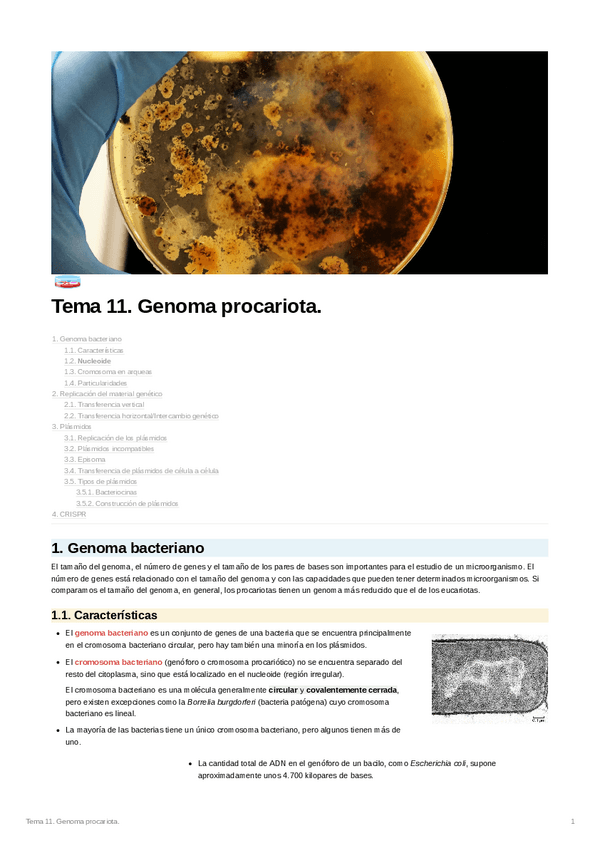

@sleep_ing
Estudios: Grado en Biología (UCM)
216 Publicaciones
8.83k Interacciones
46 Seguidores
6 Siguiendo
Lista de publicaciones de sleep_ing
apuntes
-
Temas 17-31 completo
He publicado nuevos apuntes de 2º Botánica: Temas 17-31 completo
apuntes
-
Temas 11-30 completo
He publicado nuevos apuntes de 2º Microbiología: Temas 11-30 completo
apuntes
-
Temas 1-14 completo
He publicado nuevos apuntes de 2º Regulación del Metabolismo: Temas 1-14 completo